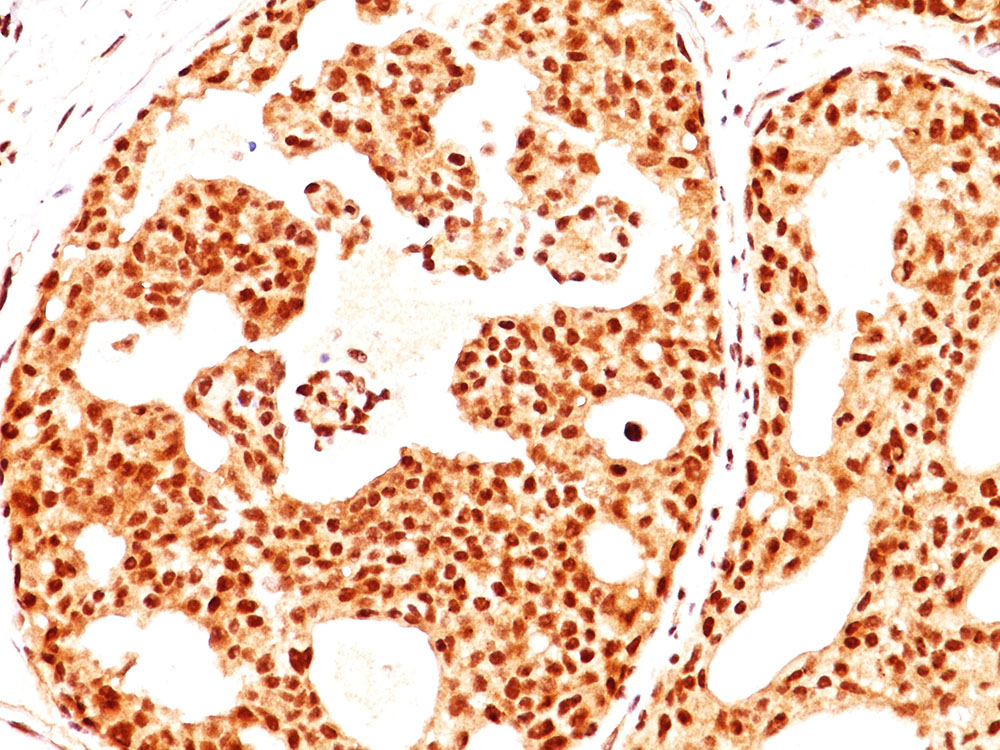

> Antigen, Antibodies, ELISA, Western Blot > Primary Antibody > Monoclonal Antibodies > ER-beta1 (Estrogen Receptor beta-1) Antibody - With BSA and AzideBrand |
Leading Biology | Catalog Number |
APR07337G |
Product Type |
Monoclonal Antibodies | Field of Research |
|
Product Overview |
We constantly strive to ensure we provide our customers with the best antibodies. As a result of this work we offer this antibody in purified format.
We are in the process of updating our datasheets. If you have any questions regarding this update, please feel free to contact our technical support team.
This product is a high quality ER-beta1 (Estrogen Receptor beta-1) antibody - With BSA and Azide.
|
||
Molecular Weight |
53-59kDa
|
||
Cellular Localization |
Antigen Cellular Localization:
Nucleus {ECO:0000255|PROSITE- ProRule:PRU00407, ECO:0000269|PubMed:19126643}
|
||
Host |
Mouse
|
||
Species Reactivity |
Human, Mouse, Rat, Monkey
|
||
Target |
C-terminus fragment of recombinant human estrogen receptor beta protein
|
||
Clone |
ERb455
|
||
Isotype |
IgG2a
|
||
Symbol |
ESTRB, NR3A2
|
||
GeneID |
|||
UniProt ID |
|||
Function |
Nuclear hormone receptor. Binds estrogens with an affinity similar to that of ESR1, and activates expression of reporter genes containing estrogen response elements (ERE) in an estrogen-dependent manner. Isoform beta-cx lacks ligand binding ability and has no or only very low ere binding activity resulting in the loss of ligand-dependent transactivation ability. DNA- binding by ESR1 and ESR2 is rapidly lost at 37 degrees Celsius in the absence of ligand while in the presence of 17 beta-estradiol and 4-hydroxy-tamoxifen loss in DNA-binding at elevated temperature is more gradual.
|
||
Summary |
Estrogen receptors (ER) are members of the steroid/thyroid hormone receptor superfamily of ligand-activated transcription factors. Estrogen receptors, including ER-alpha and ER-beta, contain DNA binding and ligand binding domains and are critically involved in regulating the normal function of reproductive tissues. They are located in the nucleus, though some estrogen receptors associate with the cell surface membrane and can be rapidly activated by exposure of cells to estrogen. ER-alpha and ER-beta are differentially activated by various ligands. Receptor-ligand interactions trigger a cascade of events, including dissociation from heat shock proteins, receptor dimerization, phosphorylation and the association of the hormone activated receptor with specific regulatory elements in target genes. Evidence suggests that ER-alpha and ER-beta may be regulated by distinct mechanisms even though they share many functional characteristics.
|
||
Form |
0.5 ml at 200ug/ml with BSA and azide |
||
Storage & Stability |
Store at +4°C short term. For long-term storage, aliquot and store at -20°C or below. Stable for 12 months at -20°C. Avoid repeated freeze-thaw cycles.
|
||
Applications |
WB, IHC, IF, FC, IP, E
|
||
Synonyms |
Estrogen receptor beta, ER-beta, Nuclear receptor subfamily 3 group A member 2, ESR2, ESTRB, NR3A2
|
||
Images |
Formalin-fixed, paraffin-embedded breast cancer stained with Estrogen receptor beta Ab (ERb455). 
Formalin-fixed, paraffin-embedded ovarian cancer stained with Estrogen receptor beta Ab (ERb455). |
||
Specification |
|||
Quantity |
|
||
| Select | Brand | Catalog No. | Product Name | Pack Size | Type | Field of Research | Specification | Quantity | Price(USD) | |
| 1 | Leading Biology | APG02467G | CCK4 / PTK7 Antibody (clone 4F9) | 50 μl | Monoclonal Antibodies |
|
$495.00 | Add Ask | ||
| 2 | Leading Biology | AMM04683G | GALT Antibody (clone 4C11) | 50 μg | Monoclonal Antibodies |
|
$545.00 | Add Ask | ||
| 3 | Leading Biology | AMM01402G | Vimentin (Mesenchymal Cell Marker) Antibody - With BSA and Azide | 50 ug | Monoclonal Antibodies |
|
$395.00 | Add Ask | ||
| 4 | Leading Biology | APR08280G | LTA4H / LTA4 Antibody (clone 9G8) | 50 μl | Monoclonal Antibodies |
|
$495.00 | Add Ask | ||
| 5 | Leading Biology | AMM00172G | CD1a / HTA1 (Mature Langerhans Cells Marker) Antibody - With BSA and Azide | 50 ug | Monoclonal Antibodies |
|
$395.00 | Add Ask | ||
| 6 | Leading Biology | AMM05750G | CEBPA Antibody | 100 μl | Monoclonal Antibodies |
|
$545.00 | Add Ask |
 Leading Biology Inc.
2600 Hilltop DR, Building G, B Suite C138
Richmond, CA, 94806
Tel: 1-661-524(LBI)-0262
Email: info@leadingbiology.com
Leading Biology Inc.
2600 Hilltop DR, Building G, B Suite C138
Richmond, CA, 94806
Tel: 1-661-524(LBI)-0262
Email: info@leadingbiology.com
Complete this form and click send to ask us a question, request a quote or simply say hello.

You have 0 item in your cart

You have 0 item in your inquiry list
